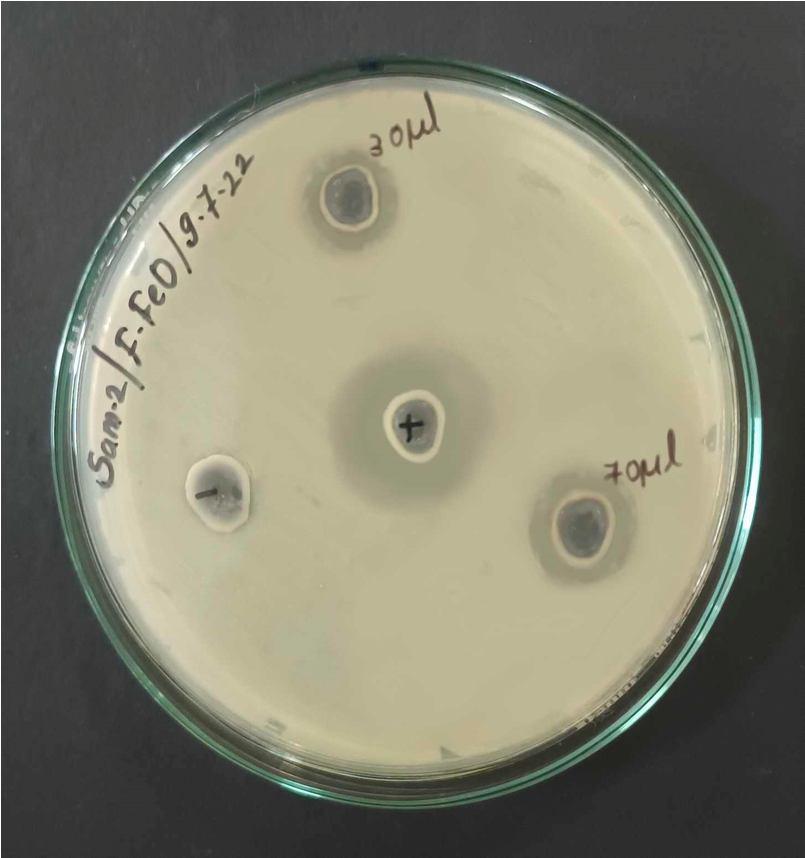
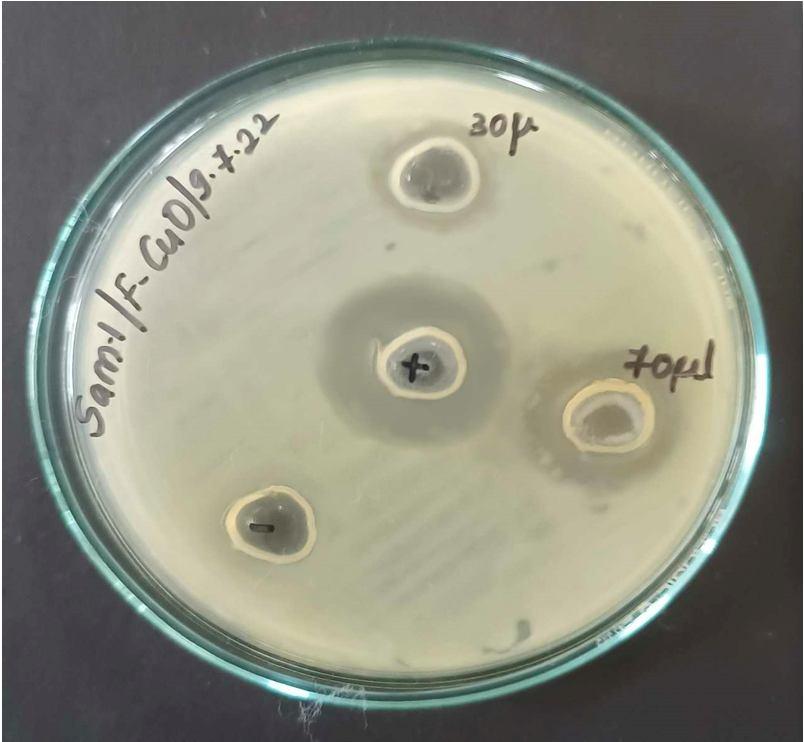
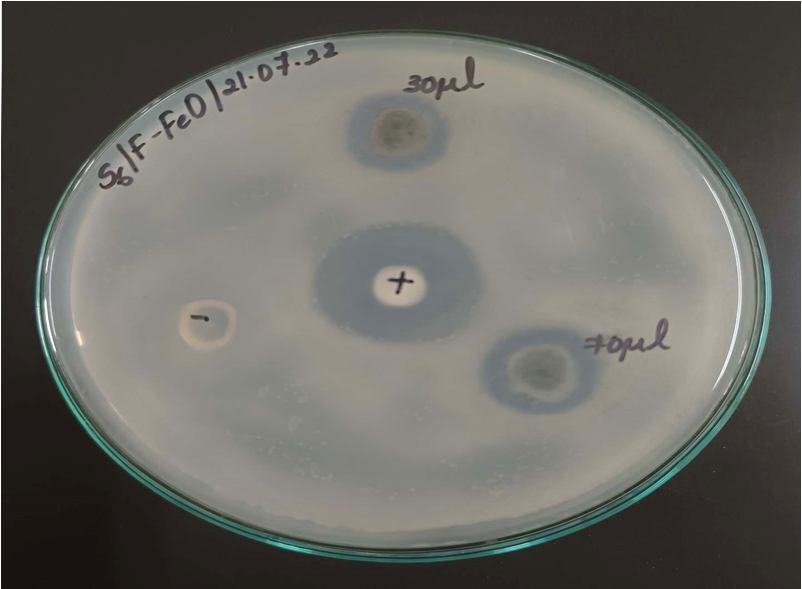
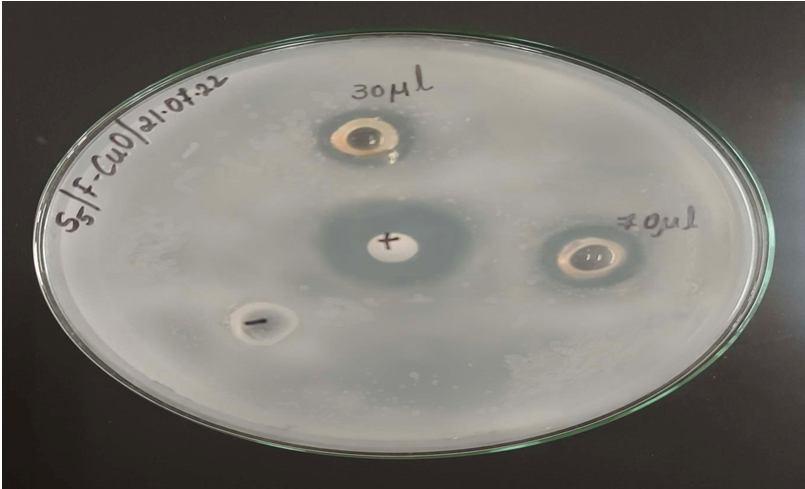
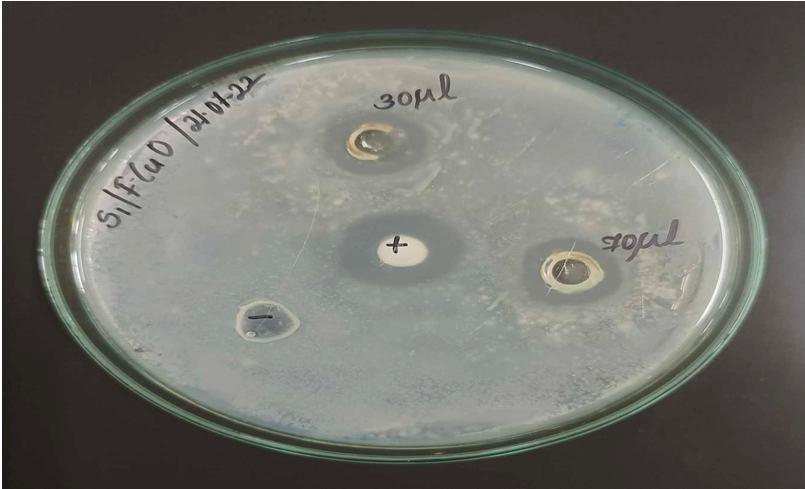

ISSN: 2321 9653; IC Value: 45.98; SJ Impact Factor: 7.538

Volume 10 Issue X Oct 2022 Available at www.ijraset.com


ISSN: 2321 9653; IC Value: 45.98; SJ Impact Factor: 7.538

Volume 10 Issue X Oct 2022 Available at www.ijraset.com
Abstract: Nanoparticles can be synthesised in an easy and eco friendly methods using plant extracts. The present study deals with green synthesis and characterization of Copper oxide and Iron oxide nanoparticles using Plumbago auriculata floral extract. In this report, aqueous phase green synthesis of specifically copper oxide and iron oxide nanoparticles utilising the floral parts of this plant is elucidated for the first time. Aqueous floral extract of fresh flowers were utilised for the synthesis of nanoparticles. The aqueous extract acts as both reducing and capping agent. The synthesised oxide nanoparticles of copper and iron were confirmed by the change of colour after addition of floral extracts into CuSO4.5H2O and FeCl3.6H2O solutions respectively. The synthesised nanoparticles were characterised by UV Visible Spectroscopy and Scanning Electron Microscopy(SEM). The UV/VIS spectroscopy showed the absorption peaks at 346nm and 348nm for Copper oxide and Iron Oxide nanoparticles prepared respectively. CuONPs and IONPs nanoparticles were validated by the SEM analysis and the average size of certain selected particles ranged from 120nm to 200nm. It was observed that the aqueous floral extract can reduce copper and iron ions into oxide nanoparticles within a day. Thus, nanoparticles can be synthesised in a sustainable and nontoxic manner by this method.
Keywords: Green synthesis, Nanoparticles, Plumbago auriculata Lam., Aqueous floral extract, Copper oxide, Iron oxide
Nanoparticles are microscopic particles whose size is measured in nanometers [1] and nanostructures have led to revolutionary developments in many scientific fields [2]. Nanoparticles are a topic of intense scientific interest since they have a wide range of potential uses in industries including electronics, optics, agriculture, biomedicine, etc. The shape and size of nanomaterials are directly related to many of the intriguing features of nanoparticles. The proportion of surface atoms in nanoparticles is high, and they exhibit shape dependent features that are used in catalysis, optics, data storage, etc. Additionally, nanoparticles are well suited for use in a variety of disciplines due to their physical characteristics, such as melting point, density, optical characteristics, electrical conductivity, chemical stability, etc. Numerous nanoparticles have been thoroughly examined and put to use in various applications, such as for gold and silver nanoparticles, while research is still underway to look into potential uses in a variety of other sectors [3]. Metal oxide nanoparticles have drawn attention due to their unique and uncommon physical and chemical properties [4]. The importance of metal oxide nanoparticles in a variety of sectors, including material chemistry, medicine, agriculture, information technology, biomedicine, optics, electronics, catalysis, environment, and energy, among others, makes them as prominent materials [5], [6].
Among the earliest metals used by humans was that of copper. The primary basis for this is that it is a native metal, which implies that it may be found naturally in a usable form, and that it possesses beneficial metallurgical qualities. Great electrical conductivity, high ductility, good heat conductivity, and corrosion resistance are all advantages of copper. However, it is also helpful in the medical profession. Before the science of bacteria was fully comprehended, centuries ago, people intuitively sensed copper's antimicrobial capabilities. Water carrying vessels that were made from copper were less prone to algal growth and slime formation than other metals [7].
Copper's antibacterial capabilities are still being studied by scientists, and many think they may be able to address the issue of resistant germs spreading in hospitals [8]. Apart from that copper nanoparticles are of great interest due to easy availability, low cost, and their similar properties to those of noble metals [9], [10]. CuNPs can also be used in sensors, heat transfer systems [11], and electronics (fuel cell and solar cell), as catalysts in many reactions [12], [13].Therefore it is assumed that CuONPs could inherit these properties.

ISSN: 2321 9653; IC Value: 45.98; SJ Impact Factor: 7.538 Volume 10 Issue X Oct 2022 Available at www.ijraset.com

Iron is an essential component for plants and animals. In the case of humans, iron is an essential part of haemoglobin; the red colouring agent of the blood that transports oxygen through our bodies. Due to its widely varied oxidation states, crystal formations, low cost, magnetic capabilities, and environmentally benign makeup, iron oxide has received much research [14]. Therefore, numerous scholars chose to investigate iron oxide nanoparticles (IONPs) because of its intriguing features and wide range of uses, including bioremediation, diagnostics, cosmetics, and biomedicine [15]. Typical physical and chemical methods have been significantly replaced with biological synthesis methods using microorganisms, enzymes or plant extracts, as they are eco friendly approaches [16]. Chemical synthesis has been found to be costly, toxic and potentially dangerous to the environment [17]. Using plants for biosynthesis of nanoparticles is a particularly useful approach than other biological ways as it eliminates the challenges associated with microbial culture maintenance [18]. Nanomaterials synthesized using plant extracts exhibit enhanced properties which could be of great interest to us instead of their bulk counterparts [19]. The amount of accumulation of NPs varies with reduction potential of ions, and the reducing capacity of plant depends on the presence of various polyphenols and other heterocyclic compounds [20].
Due to increasing popularity in the use of plant extracts, we have used the floral extracts of Plumbago auriculata plant in this project for the synthesis of desired nanoparticles. This plant has been mostly found in South Africa's tropical and subtropical regions and is a native of that country. Thus it is frequently encountered around the Southern and Eastern Capes. These days, it is grown in Sri Lanka, China, Southern Europe, and England as well. In India, this plant is considered as one of the important medicinal plants by the local tribes of Maharashtra and is cultivated as outdoor and indoor ornamental plant. Plumbago auriculata (‘Nila chitrak’ in Hindi) is basically a scrambling shrub with tons of health benefits and mesmerising blue flowers. It grows up to 5 10ft in height and the shrub is dark green in colour but after maturity it changes its colour to light brown. The leaves have a delicate texture, green in colour, and tiny gland spots. The underside of the plant's leaves is covered in a white residue. Beautiful blue flowers are produced by the shrub, which blooms in the summer. Plumbago often flowers all year round, with the exception of the harshest winter months. This shrub's flowers include glandular hairs that release mucilage, a sticky substance that aids in trapping tiny insects. Fruits are capsules that split into five parts.
The Latin word "Plumbum," is the source from which the English name "Plumbago" is derived, it refers to an effective treatment for lead poisoning. The medicinal plant Plumbago contains a very potent secondary metabolite called ‘plumbagin’, which has many therapeutic properties. The plant's root, bark, and aerial portions are used for their herbal medicinal properties since they contain a variety of chemical components. In Ayurveda, it is used to cure a wide range of illnesses, including inflammation, fever, headaches, toothaches, and excruciating physical pain. It has anti oxidant properties, acts as an analgesic, and also stimulates the neurological system [21].
Analytical grade copper sulphate pentahydrate (CuSO4.5H2O) and ferric chloride hexahydrate (FeCl3.6H2O) chemicals were used in this study without any further purification
Flowers of Plumbago auriculata were collected from Yuvaraja’s College campus, University of Mysore, Mysuru.
Weigh 20g of fresh flowers and wash them thoroughly in distilled water for a few minutes. The washed flowers are dried, chopped into fine pieces and boiled in 100ml of distilled water for 15minutes in a 500ml borosil beaker. The extract obtained was filtered through muslin cloth and then through Whatmann no: 1 filter paper (pore size 25μm) and used immediately for the biosynthesis of copper oxide and iron oxide nanoparticles.
For the synthesis of CuONPs, 5ml of fresh flower extract was added to 25ml of 1% aqueous copper sulphate in 250 ml borosil conical flask at room temperature. The colour of the extract changes from light purple to greenish brown in colour indicating the formation of CuONPs. This solution is placed inside a BOD incubator, where it is left in the shade for 24 hours to allow the reactions to complete

ISSN: 2321 9653; IC Value: 45.98; SJ Impact Factor: 7.538

Volume 10 Issue X Oct 2022 Available at www.ijraset.com
FeCl3.6H2O was used as the precursor for the synthesis of the iron oxide nanoparticles. The synthesis of iron oxide nanoparticles was done by adding 0.01 M Ferric chloride and the fresh flower extract in 1:1 proportion separately in clean sterilised flasks. The solution resulting from the addition of flower extract and 0.01 M Ferric Chloride was blackish brown in colour. There was an immediate colour change of the floral extract after its addition into the ferric chloride solution. The solution is left in shade, inside a BOD incubator for 24 hours for the reactions to get completed.

To collect the nanoparticle samples, the reaction mixture was centrifuged two times at 4000rpm for 10 min and washed twice with distilled water and alcohol respectively. The obtained greenish brown colour samples of copper oxide and blackish brown colour samples of iron oxide was then dried in a vacuum drier. The product obtained is grounded to fine powder.
All ultraviolet visible (UV vis) spectra were recorded on the Beckman Coulter DU 730 UV vis spectrophotometer. The absorption spectra of the prepared NPs was recorded by taking the aqueous dispersion of the NPs and scanned in the range of 200 900 nm, operated at the resolution of 1nm. Distilled water was taken to adjust the baseline. Scanning electron microscopy (SEM) was used study the morphological features of synthesised nanoparticles. SEM images were recorded using Carl Zeiss Germany,Model : EVO MA 15 SEM instrument at the IOE Research Facility of University of Mysore, India.
Escherichia coli and Bacillus subtilis species were collected from the Dept. of Microbiology, Yuvaraja's college, University of Mysore The sub cultures were maintained using nutrients agar media for further use. The zone of inhibition was calculated using the agar plate well diffusion method. E. coli and Bacillus subtilis were cultured in nutrient agar broth and kept at 37 0C for the duration of a night. The experiment made use of this overnight culture of bacteria in nutrient broth. For each bacterium in this procedure, a sterilised nutrient agar plate was used. Then using a sterile cotton swab, these two bacterial pathogens were applied to the agar plates. These plates were then given time to dry. A sterile cork borer of approximately 8.0 mm diameter was then used to drill four wells in each agar plate. The suspension of the antibiotic streptomycin (0.1ml of 25 μg/ml), distilled water, 30 μl and 70 μl of the produced NPs stock solutions (1 mg/ml) were then added to these dug wells separately for each strain. DMSO was used to prepare the stock solutions. Distilled water served as the negative control, and the antibiotic served as the positive control. The plates were left in place for 1 hour to allow for complete diffusion, then incubated for 24 hrs at 37 0C and measured the diameter of inhibitory zones in millimetres.
The fungal species Aspergillus niger and Fusarium oxysporum were collected from the Dept. of Microbiology, Yuvaraja’s college, University of Mysore The sub cultures were maintained using potato dextrose agar media for further use. The agar well diffusion method was used to assess the NPs antifungal activity.
The prepared fungal inoculums were utilised to evaluate the antifungal activity of the NPs. 20 ml of the prepared potato dextrose agar medium was added to each of the 90 mm Petriplates. After that the petriplates were left in the laminar airflow chamber to allow the media to get solidified. The spread plate technique was used to inoculate the petriplates and 0.5ml of the fungal inoculum was used for each plate.
Then three wells were made on the agar plate using a 8 mm standard cork borer. To each well, different concentrations of NPs (30 and 70 μl of 0.30 mg/ml NPs) and distilled water (negative control) were added. DMSO was used to prepare the stock solutions of synthesised nanoparticles. Standard sterile discs presoaked in Bavistin (1ml of 25 μg/ml) were used as positive control. The plates were then sealed and incubated for two days at room temperature. After that, the impact of NPs on fungal pathogens was assessed and compared to the reference standard antibiotic disc employed in the current investigation. Finally, the zone of inhibition was measured using a standard scale to determine the antifungal activity.
ISSN: 2321 9653; IC Value: 45.98; SJ Impact Factor: 7.538 Volume 10 Issue X Oct 2022 Available at www.ijraset.com

Fig. 1: Various steps involved in the preparation of NPs sample: (a) image of the flowers, (b) floral extract, (c) 1% CuSO4, (d) 0.01 M FeCl3.6H2O, (e) formation of CuONPs (f) formation of IONPs, (g) finely crushed CuONPs nanoparticles, (h) finely crushed IONPs nanoparticles

Copper sulphate was used as a precursor in the synthesis of the CuONPs, and fresh flower extract served as reducing and capping agent. Visually, the transformation of the solution's colour from light blue to greenish brown indicates the formation of copper oxide nanoparticles. To get rid of any undesirable particles, distilled water and then ethanol were used to wash the synthesized CuONPs. CuONPs was then dried, crushed, and characterized using a variety of techniques.


For the synthesis of IONPs, the different phytochemicals included in the fresh floral extract function equally as reducing and stabilising agents. Due to the interaction of these phytochemicals with metal ions, which enabled the creation of iron oxide nanoparticles, black coloured precipitates were produced. When iron salt solution and floral extracts are combined under specific reaction circumstances, Fe3+ cannot be reduced to Fe0; instead, iron oxide nanoparticles (IONPs) are produced as a result of a reaction between the iron ions and phytochemicals [22].
One of the most essential characterization techniques for studying nanoparticles is UV Vis analysis. By using a UV Vis Spectrophotometer, the surface plasmon resonances (SPR) of synthesised oxide nanoparticles has been investigated. The stimulation of SPR causes the absorption of visible radiation, which gives nanoparticles their distinct colours. The colour of the solution is also expected to alter as the size of the nanoparticles changes. Therefore, the production of nanoparticles is extremely sensitive to the UV Vis absorption spectrum. The UV Vis spectra of each of the samples is displayed in Fig. 2 The highest peak bands of copper oxide nanoparticles was observed at 346 nm and that of iron oxide nanoparticles was at 348 nm. Pure Cu NPs have a peak near 590 nm, and CuONPs exhibit a peak in the region of 250 nm, according to the studies in the various literature. CuONPs are thought to make up the majority of the synthesised particles because the measured UV results for the synthesised copper particles are closer to the latter. The same is true for IONPs, as multiple literature reviews indicate that their peak observations fall within a range of 250 350 nm. a b
Fig 2: UV Visible spectrum of (a) CuONPs, (b) IONPs
ISSN: 2321 9653; IC Value: 45.98; SJ Impact Factor: 7.538 Volume 10 Issue X Oct 2022 Available at www.ijraset.com
Further data about the morphology and size specifics of the produced nanoparticles was revealed by scanning electron microscopy. The typical SEM image reveals that the product largely contained copper oxide and iron oxide nanoclusters with a panoramic perspective, and the size of some chosen particles measured between 120 and 200 nm. Using Image J software, the nanoparticles were measured from the SEM image. Average size of the selected CuONPs and IONPs was found to be 146nm and 180nm respectively. The distorted shape of the nanoparticles with their smooth and jagged edges is shown in the SEM photos. Due to the plant extract's sticky nature, SEM revealed that the nanoparticles have become slightly agglomerated. The SEM micrographs taken at low resolution is depicted in the inset of Fig. 3. Small nuclear particles are self aggregated and orient themselves to form larger particles a b


Fig. 3: SEM images of (a) CuONPs, (b) IONPs

The antibacterial activity of green synthesised nanoparticle suspensions of different concentrations was done against a gram negative and gram positive bacteria such as E.Coli and Bacillus subtilis. The antibacterial agents (NPs) were put to the test for its capacity to rupture bacterial cells using the well diffusion method. In Table 1 & 2, the antibacterial activity investigated against gram negative and gram positive bacteria at different sample concentrations is depicted.
Table 1: Antibacterial activity of copper oxide nanoparticles Inhibition zone (mm)
Microbial culture +ve control ve control 30µl 70µl
Escherichia coli 24 0 16 17 Bacillus subtilis 25 0 17 19
Table 2: Antibacterial activity of iron oxide nanoparticles Inhibition zone (mm)
Microbial culture +ve control ve control 30µl 70µl

Escherichia coli 24 0 13 15 Bacillus subtilis 25 0 15 17
According to some researchers, the antibacterial characteristics of nanoparticles are a result of their nanoscale size, which enables them to aggregate or deposit on the surface of the bacterial strains under study [23] [25]. Due to the existence of phytochemical components, plant extracts may possibly have antibacterial activity in addition to the NPs [26]. To understand the precise mechanism of NPs against bacterial strains, there are a variety of hypotheses that are involved.
ISSN: 2321 9653; IC Value: 45.98; SJ Impact Factor: 7.538 Volume 10 Issue X Oct 2022 Available at www.ijraset.com

One of the proposed mechanism involves the association of copper with oxygen and its reaction with sulfhydryl ( S H) groups on the cell wall to form R S S R bonds, thereby blocking respiration and causing cell death. In general, the production of reactive oxygen species (ROS), oxidative stress brought on by ROS, and the interaction of ions released by nanoparticles, with thiol groups ( SH) of the bacterial cell caused the iron oxide nanoparticles to exhibit their antibacterial properties. This alters the structure of the microorganisms and prevents DNA replication and protein synthesis [27], [28]. The existence of an inhibitory zone strongly suggests that membrane disruption is a component of the biocidal activity of nanoparticles. The degree of suppression is dependent on both the initial bacterial concentration and the nanoparticles concentration. The smaller size of the particles may cause them to adhere more closely to the surface of the bacterial cells, breaking the membrane and allowing internal components to leak out, killing the bacterial cells.

a b
Fig 4: The antibacterial effect of CuONPs on pathogens (a) E. coli & (b) B. subtilis a b
Fig 5: The antibacterial effect of IONPs on pathogens (a) E. coli & (b) B. subtilis

The fungi F. oxysporum and A. niger were used as role model fungi to test the antifungal activities of IONPs.The well diffusion method was used to test the ability of the antifungal agent (NPs) against the fungal cells. The antifungal activity studied against the fungal species at different concentrations of samples are shown in Table 3 & 4.
ISSN: 2321 9653; IC Value: 45.98; SJ Impact Factor: 7.538 Volume 10 Issue X Oct 2022 Available at www.ijraset.com

Table 3: Antifungal activities of copper oxide nanoparticles Inhibition zone of microbes (mm)
Microbial culture +ve control ve control 30µl 70µl
Fusarium oxysporum 22 0 15 17 Aspergillus niger 23 0 14 14

Table 4: Antifungal activities of iron oxide nanoparticles Inhibition zone (mm)


Microbial culture +ve control ve control 30µl 70µl
Fusarium oxysporum 24 0 14 15 Aspergillus niger 25 0 16 15
Because NPs have a high surface to volume ratio, they can firmly cling to fungal cell surfaces. Additionally, because of its small size, it can enter cells directly harming the cell wall. When NPs directly interact with cell surfaces, they alter the permeability of the membranes thereby causing oxidative stress in fungal cells, which ultimately leads to the suppression of cell development and eventually cell death [29]. A recent literature has discussed the potential for membrane damage brought on by direct or electrostatic interaction between iron oxide nanoparticles and cell surfaces, cellular internalisation of NPs, and the generation of active oxygen species such H2O2 in cells as a result of metal oxides [30]. Moreover, iron oxide NPs synthesised using Plumbago auriculata showed significant antifungal activities against both F.oxysporum and A.niger as displayed in Fig 6 7
ISSN: 2321 9653; IC Value: 45.98; SJ Impact Factor: 7.538 Volume 10 Issue X Oct 2022 Available at www.ijraset.com
An effective way to produce eco friendly nanomaterials for biological applications is by the green synthesis of nanoparticles utilising plant extracts. Using floral extracts from Plumbago auriculata nanoparticles were created. UV visible spectroscopy analysis was used to principally monitor the reduction of copper ions into copper oxide nanoparticles and iron ions into iron oxide nanoparticles. Using the SEM technique, particle shape and size were investigated. The synthesized CuONPs and IONPs have shown antibacterial and antifungal properties. With the observation of the obtained results, the antimicrobial capabilities of the biosynthesized CuONPs and IONPs are assumed to be promising contenders for medical applications. Consequently, the biosynthesized nanoparticles may be useful in the delivery of drugs. To characterize the biomolecules involved in the bioreduction of CuONPs and IONPs, the current research can be further expanded

The authors are thankful to the faculty of Post Graduate department of Botany, Yuvaraja’s College, University of Mysore, for providing the support and laboratory facility to conduct this research work.
[1] Nanoparticles2022. [Online]. Available: https://www.merriamwebster.com/dictionary/nanoparticle. [Accessed: 30 Sep 2022].
[2] Y. Xia, J. Rogers, K. Paul and G. Whitesides, "Unconventional Methods for Fabricating and Patterning Nanostructures", Chemical Reviews, vol. 99, no. 7, pp. 1823 1848, 1999. Available: 10.1021/cr980002q.
[3] V. Singh, S. Yadav, V. Chouhan, S. Shukla and K. Vaishnolia, Applications of Nanoparticles in Various Fields, pp. 221 23, 2020. Available: 10.4018/978 1 7998 6527 8.ch011.
[4] V. Grassian, "When Size Really Matters: Size Dependent Properties and Surface Chemistry of Metal and Metal Oxide Nanoparticles in Gas and Liquid Phase Environments", The Journal of Physical Chemistry C, vol. 112, no. 47, pp. 18303 18313, 2008. Available: 10.1021/jp806073t.
[5] M. Chavali and M. Nikolova, "Metal oxide nanoparticles and their applications in nanotechnology", SN Applied Sciences, vol. 1, no. 6, 2019. Available: 10.1007/s42452 019 0592 3.
[6] D. Ziental et al., "Titanium Dioxide Nanoparticles: Prospects and Applications in Medicine", Nanomaterials, vol. 10, no. 2, p. 387, 2020. Available: 10.3390/nano10020387.
[7] Z. Guo, X. Liang, T. Pereira, R. Scaffaro and H. Thomas Hahn, "CuO nanoparticle filled vinyl ester resin nanocomposites: Fabrication, characterization and property analysis", Composites Science and Technology, vol. 67, no. 10, pp. 2036 2044, 2007. Available: 10.1016/j.compscitech.2006.11.017.
[8] M. Gouda and A. Hebeish, "Preparation and Evaluation of CuO/Chitosan Nanocomposite for Antibacterial Finishing Cotton Fabric", Journal of Industrial Textiles, vol. 39, no. 3, pp. 203 214, 2009. Available: 10.1177/1528083709103142.
[9] Ruparelia, A. Chatterjee, S. Duttagupta and S. Mukherji, "Strain specificity in antimicrobial activity of silver and copper nanoparticles", Acta Biomaterialia, vol. 4, no. 3, pp. 707 716, 2008. Available: 10.1016/j.actbio.2007.11.006.
[10] T. Theivasanthi and M. Alagar, "Studies of Copper Nanoparticles Effects on Micro organisms", Arxiv, 2011. Available: https://arxiv.org/abs/1110.1372. [Accessed 1 October 2022].
[11] M. Černík and V. Thekkae Padil, "Green synthesis of copper oxide nanoparticles using gum karaya as a biotemplate and their antibacterial application", International Journal of Nanomedicine, p. 889, 2013. Available: 10.2147/ijn.s40599.
[12] G. Borkow et al., "Molecular mechanisms of enhanced wound healing by copper oxide impregnated dressings", Wound Repair and Regeneration, vol. 18, no. 2, pp. 266 275, 2010. Available: 10.1111/j.1524 475x.2010.00573.x.
[13] A. Umer, S. Naveed, N. Ramzan and M. Rafique, "Selection of a Suitable Method for the Synthesis of Copper Nanoparticles", Nano, vol. 07, no. 05, p. 1230005, 2012. Available: 10.1142/s1793292012300058.
[14] A. Khalil, M. Ovais, I. Ullah, M. Ali, Z. Shinwari and M. Maaza, "Biosynthesis of iron oxide (Fe2O3) nanoparticles via aqueous extracts of Sageretia thea (Osbeck.) and their pharmacognostic properties", Green Chemistry Letters and Reviews, vol. 10, no. 4, pp. 186 201, 2017. Available: 10.1080/17518253.2017.133983.
[15] M. Pattanayak and P. Nayak, "Green Synthesis and Characterization of Zero Valent Iron Nanoparticles from the Leaf Extract of Azadirachta indica (Neem)", World Journal of Nano Science & Technology, vol. 2, no. 1, pp. 6 9, 2013. Available: 10.5829/idosi.wjnst.2013.2.1.21132.
[16] S. Saif, A. Tahir, T. Asim and Y. Chen, "Plant Mediated Green Synthesis of CuO Nanoparticles: Comparison of Toxicity of Engineered and Plant Mediated CuO Nanoparticles towards Daphnia magna", Nanomaterials, vol. 6, no. 11, p. 205, 2016. Available: 10.3390/nano6110205.
[17] G. Shobha, V. Moses and A. S, "Biological Synthesis of Copper Nanoparticles and its impact a Review", International Journal of Pharmaceutical Science Invention, vol. 3, no. 8, pp. 28 38, 2014. [Accessed 1 October 2022].
[18] Y. Prabhu, K. Venkateswara Rao, V. Sesha Sai and T. Pavani, "A facile biosynthesis of copper nanoparticles: A micro structural and antibacterial activity investigation", Journal of Saudi Chemical Society, vol. 21, no. 2, pp. 180 185, 2017. Available: 10.1016/j.jscs.2015.04.002.

[19] K. Reddy, "Green synthesis, morphological and optical studies of CuO nanoparticles", Journal of Molecular Structure, vol. 1150, pp. 553 557, 2017. Available: 10.1016/j.molstruc.2017.09.005.
[20] R. Nair, S. Varghese, B. Nair, T. Maekawa, Y. Yoshida and D. Kumar, "Nanoparticulate material delivery to plants", Plant Science, vol. 179, no. 3, pp. 154 163, 2010. Available: 10.1016/j.plantsci.2010.04.012.
[21] K. Singh, Y. Naidoo, V. Bharuth and H. Baijnath, "Micromorphology and histochemistry of the secretory apparatus of Plumbago auriculata Lam.", South African Journal of Botany, vol. 121, pp. 230 238, 2019. Available: 10.1016/j.sajb.2018.10.036.
Science & Engineering Technology (IJRASET)

ISSN: 2321 9653; IC Value: 45.98; SJ Impact Factor: 7.538 Volume 10 Issue X Oct 2022 Available at www.ijraset.com
[22] H. Devi, M. Boda, M. Shah, S. Parveen and A. Wani, "Green synthesis of iron oxide nanoparticles using Platanus orientalis leaf extract for antifungal activity", Green Processing and Synthesis, vol. 8, no. 1, pp. 38 45, 2019. Available: 10.1515/gps 2017 0145.
[23] T. Varadavenkatesan, R. Selvaraj and R. Vinayagam, "Dye degradation and antibacterial activity of green synthesized silver nanoparticles using Ipomoea digitata Linn. flower extract", International Journal of Environmental Science and Technology, vol. 16, no. 5, pp. 2395 2404, 2018. Available: 10.1007/s13762 018 1850 4.
[24] G. Jagathesan and P. Rajiv, "Biosynthesis and characterization of iron oxide nanoparticles using Eichhornia crassipes leaf extract and assessing their antibacterial activity", Biocatalysis and Agricultural Biotechnology, vol. 13, pp. 90 94, 2018. Available: 10.1016/j.bcab.2017.11.014.

[25] S. Groiss, R. Selvaraj, T. Varadavenkatesan and R. Vinayagam, "Structural characterization, antibacterial and catalytic effect of iron oxide nanoparticles synthesised using the leaf extract of Cynometra ramiflora", Journal of Molecular Structure, vol. 1128, pp. 572 578, 2017. Available: 10.1016/j.molstruc.2016.09.031.
[26] S. Vasantharaj, S. Sathiyavimal, P. Senthilkumar, F. LewisOscar and A. Pugazhendhi, "Biosynthesis of iron oxide nanoparticles using leaf extract of Ruellia tuberosa: Antimicrobial properties and their applications in photocatalytic degradation", Journal of Photochemistry and Photobiology B: Biology, vol. 192, pp. 74 82, 2019. Available: 10.1016/j.jphotobiol.2018.12.025.
[27] M. Arakha et al., "Antimicrobial activity of iron oxide nanoparticle upon modulation of nanoparticle bacteria interface", Scientific Reports, vol. 5, no. 1, 2015. Available: 10.1038/srep14813.
[28] Z. Luo, Y. Qin and Q. Ye, "Effect of nano TiO2 LDPE packaging on microbiological and physicochemical quality of Pacific white shrimp during chilled storage", International Journal of Food Science & Technology, vol. 50, no. 7, pp. 1567 1573, 2015. Available: 10.1111/ijfs.12807.
[29] Y. Xie, Y. He, P. Irwin, T. Jin and X. Shi, "Antibacterial Activity and Mechanism of Action of Zinc Oxide Nanoparticles against Campylobacter jejuni", Applied and Environmental Microbiology, vol. 77, no. 7, pp. 2325 2331, 2011. Available: 10.1128/aem.02149 10.
[30] Y. Liu, L. He, A. Mustapha, H. Li, Z. Hu and M. Lin, "Antibacterial activities of zinc oxide nanoparticles against Escherichia coli O157:H7", Journal of Applied Microbiology, vol. 107, no. 4, pp. 1193 1201, 2009. Available: 10.1111/j.1365 2672.2009.04303.x.
